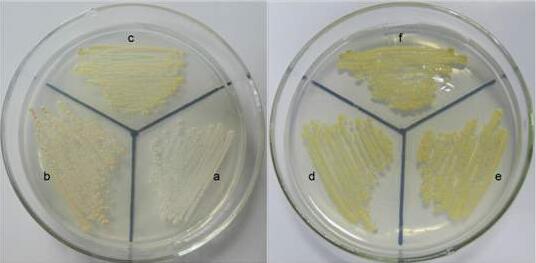
产品封面图

万千商家帮你免费找货
0 人在求购买到急需产品
- 详细信息
- 询价记录
- 文献和实验
- 技术资料
- 库存:
20
- 英文名:
Porphyromonas gingivalis
- 保质期:
详见说明书
- 供应商:
上海西格
- 保存条件:
2-8℃冷藏
- 规格:
详见说明书
1、牙龈卟啉单胞菌培养微生物菌种应保藏在干燥低温和清洁之处,在室温环境内的放置时间不宜过长。
2、应在无菌环境下进行操作,以防止杂菌污染。
3、斜面菌种保存时间通常为3-6个月,冻干菌种保藏时间通常为2-15年。
资源名称 牙龈卟啉单胞菌培养
种属 Porphyromonas gingivalis
分离基物 人类龈沟
提供形式 冻干管,斜面培养物
安全等级 1
模式菌株 yes
应用领域 模式菌株,质量控制菌株
培养方法
培养基 TSA+5%脱纤维羊血:胰蛋白胨(酪蛋白胰酶消化物) 15.0g,大豆蛋白胨(大豆粉木瓜蛋白酶消化物) 5.0g,氯化钠 5.0g,琼脂 15.0g,5%脱纤维羊血,pH7.3±0.2。121℃,15min。
传代方法 ①冻干管:75%酒精擦拭管壁,后用砂轮在冻干管壁划两圈,掰断,用200μL无菌水或培养基充分溶解,平板涂布,活化培养。 ②斜面:试管口用75%酒精擦拭后,火焰灼烧,后用无菌接种铲切块,挑取接入平板或斜面,培养。
生长条件 37℃,厌氧。
存储条件 2-8℃冷藏
微生物菌种保藏方法:
一)定期移植保藏法
即传代培养保藏法,包括斜面培养、穿刺培养、液体培养等。是指将菌种接种于适宜的培养基中,最适条件下培养,待生长充分后,于4℃-6℃进行保存并间隔一定时间进行移植培养的菌种保藏方法。
二)液体石蜡保藏法
也叫矿物油保藏法,是指将菌种接种在适宜的斜面培养基上,最适条件下培养至菌种长出健壮菌落后注入灭菌的液体石蜡,使其覆盖整个斜面,再直立放置于4℃-15℃进行保存。
三)沙土管保藏法
亦称载体保藏法,具体方法是将培养好的微生物细胞或孢子用无菌水制成悬浮液,注入灭菌的沙土管中混合均匀,或直接将成熟孢子刮下接种于灭菌的沙土管中,使微生物细胞或孢子吸附在载体上,将管中水分抽干后熔封管口或置干燥器中于4℃-15℃进行保存。
保藏方法与步骤:
一)培养基制备
1.准备器皿,如三角瓶、试管、培养皿、烧杯、吸管等,根据不同情况洗涤、干燥、包装、灭菌。
2.溶解培养基配料:先在烧杯中放适量水,按培养基配方称取各项材料,依次将缓冲化合物、主要元素、微量元素、维生素等材料加入水中溶解,最后加足水量。
3.调pH值;
4.加凝固剂,如琼脂、明胶等。将凝固剂加入液体培养基中,加热并不断搅拌至融解,再补足所蒸发水分。
5.过滤分装;
6.包扎标记;
7.灭菌;
8.无菌检查。
二)接种
1.斜面接种
根据菌种的不同性征,可选择不同的方法,如点接、中央划线、稀波状蜿蜒划线法、密波状蜿蜒划线法、挖块接种法等;
2.穿刺接种
用直接种针从原菌种斜面上挑取少量菌苔,从柱状培养基中心自上而下刺入,直到接近管底(勿穿到管底),然后沿原穿刺途径慢慢抽出接种针。适用于细菌和酵母菌等。
3.液体接种
挑取少量固体斜面菌种或用无菌滴管等吸取原菌液接种于新鲜液体培养基中。
三)培养
将接种后的培养基放入培养箱中,在适宜的条件下培养至细胞稳定期或得到成熟孢子。
四)保藏
1.保藏温度和时间:4℃-6℃保存,根据要求每 3-6 个月移植一次。对于某些菌种,如芽裂酵母,阿舒假囊酵母,棉病囊霉等,须 1-3 个月移植一次。
2.保藏湿度 :用相对湿度表示,通常为 50%-70%。测量仪表采用毛发湿度计或干湿球湿度计。
五)移植培养
将培养物转接到另一新鲜培养基中,再在适宜条件下培养。
六)复壮
菌种如有退化,应将退化的菌种引入原来的生活环境中令其生长繁殖,通过纯种分离,在宿主体内生长等方法进行复壮。
胃癌相关抗原mg检测试剂盒 mgs MGS 3.75 120 U/mL 0.1
血管内皮生长因子抗体检测试剂盒 VEGF-Ab Vascular Endothelial cell Growth Factor antibody 0.625 20 ng/mL 0.1
CXC趋化因子配体5检测试剂盒 CXCL5 CXC-chemokine ligand 5 12.5 400 pg/mL 1
血小板生成素受体检测试剂盒 TPOR Thrombopoietin Receptor 12.5 400 pg/mL 1
脑膜炎奈瑟氏球菌IgM抗体检测试剂盒 GCMC-IgM N.meningitidis IgM 5 160 ng/mL 1
黑色素瘤相关抗原D4检测试剂盒 MAGED4;MAGED4B Melanoma-associated antigen D4 62.5 2000 pg/mL 10
白细胞介素1受体样1检测试剂盒 IL-1RL1 Interleukin 1 Receptor1 12.5 400 pg/ml 1
黑色素瘤相关抗原D4抗体检测试剂盒 MAGED4-Ab;MAGED4B-Ab Melanoma-associated antigen D4 antibody 5 160 ng/mL 1
胱抑素SN检测试剂盒 CST1 Cystatin-SN 0.3125 10 ng/ml 0.1
肌球蛋白ⅦA检测试剂盒 MYO7A Myosin-VIIA 62.5 2000 pg/mL 10
钠-葡萄糖协同转运蛋白2检测试剂盒 SGLT2 sodium glucose co-transporter 2 1.5 48 ng/mL 0.1
趋化因子配体12检测试剂盒 CXCL12 CXC-chemokine ligand 12 0.25 8 ng/mL 0.1
周期素依赖性激酶11检测试剂盒 CDK-11 Cyclin-dependent kinase 11 75 2400 pg/mL 10
巨噬细胞集落刺激因子1受体检测试剂盒 CSF1R colony-stimulating factor receptor 1 0.75 24 ng/mL 0.1
盘状结构域受体家族成员1检测试剂盒 DDR1 Epithelial discoidin domain-containing receptor 1 0.25 8 ng/mL 0.1
血管内皮生长因子受体1检测试剂盒 VEGFR1;FLT1 Vascular endothelial cell growth factor receptor 1 150 4800 pg/mL 10
血管内皮生长因子受体4检测试剂盒 VEGFR4;FLT4 Vascular endothelial cell growth factor receptor 4 0.3125 10 ng/ml 0.1
视黄醇检测试剂盒 Ret Retinol 0.25 8 ug/mL 0.1
鳞状细胞癌相关抗原2检测试剂盒 SCC-Ag2 squamous cell carcinoma related antigen2 125 4000 pg/mL 10
神经营养素受体P75检测试剂盒 p75NTR p75 neurotrophin receptor 0.625 20 ng/mL 0.1
低氧诱导因子1检测试剂盒 HIF1 hypoxia-inducible factor1 200 6400 pg/mL 10
精浆弹性硬蛋白酶检测试剂盒 PMN-Elastase PMN-Elastase 2.5 80 ng /ml 0.1
精浆弹性硬蛋白酶检测试剂盒 PMN-Elastase PMN-Elastase 12.5 400 ng /ml 1
糖类抗原15-3检测试剂盒 CA15-3 CA15-3 7.5 240 U/ml 1
半乳糖苷酶检测试剂盒 GAL galactosidase 2 64 U/mL 0.1
半胱氨酰白三烯检测试剂盒 CysLTs Cysteinyl leukotriene 200 6400 pg/mL 10
DDX4检测试剂盒 DDX4 Probable ATP-dependent RNA helicase DDX4 125 4000 pg/mL 10
基膜聚糖;内腔蛋白检测试剂盒 LUM lumican 1.25 40 ng/mL 0.1
牙龈卟啉单胞菌培养前肾素检测试剂盒 Prorenin Prorenin 3.125 100 ng/mL 0.1
肾素前体检测试剂盒 REN precursor renin precursor 12.5 400 ng/ml 1
RNA结合基元蛋白8A检测试剂盒 RBM8A RNA-binding protein 8A 0.25 8 ng/mL 0.1
半胱氨酰白三烯受体检测试剂盒 CYSLTR Cysteinyl leukotriene receptor 62.5 2000 pg/mL 10
尿皮质素检测试剂盒 UCN Urocortin 12.5 400 pg/mL 1
类免疫缺陷病毒抗体1+2检测试剂盒 HIV-Ab 1+2 Immunodeficiency virus Antibody 1+2 0 10
高密度脂蛋白2b检测试剂盒 HDL2b High density lipoprotein 2b 0.3125 10 mmol/L 0.1
风险提示:丁香通仅作为第三方平台,为商家信息发布提供平台空间。用户咨询产品时请注意保护个人信息及财产安全,合理判断,谨慎选购商品,商家和用户对交易行为负责。对于医疗器械类产品,请先查证核实企业经营资质和医疗器械产品注册证情况。
- 作者
- 内容
- 询问日期
文献和实验作者:陈众 卷首语 在微生物检验工作中,痰标本是一个最为复杂、棘手的问题,如何规范做好痰标本细菌培养,是很多微生物检验工作者关心的,今天我们就“痰”论一下。 一、温习基本概念 1、正常菌群:指定居在人类皮肤及粘膜上的各类非致病微生物,非但无害,而且具有拮抗某些病原微生物和提供某些营养物的作用。 2、条件致病微生物:原本属于正常菌群不会引起疾病,由于机体抵抗力下降,微生物寄居部位改变或菌群失调,该菌可致病,大多是由于大量使用广谱抗生素和免疫抑制剂导致。 3、病原微生物:能引起
由绿脓假单胞菌培养物中产生的绿色色素。培养基因为有此色素而呈绿色。它可发生可逆的氧化还原作用,氧化型呈蓝色(碱性时)和红色(酸性时),变色点的 pK= 5.0;还原型无色,但在酸性条件下出现氧化还原的中间阶段(绿色)。氧化还原电位 Eo ′ =-0.034V( pH=7)。
不解糖、不耐 2% 胆盐的菌株(如牙龈类杆菌等)已独立成一新属,称为卟啉菌属( porphyromonas )。包括有 3 种,分别是牙龈卟啉菌 (p.gingvalis) 、不解糖卟啉菌 (p.assacharolytica) 、牙髓卟啉菌 (p.endodontalis) 。革兰氏阴性杆菌或球杆菌,专性厌氧,无芽胞,无动力。肉汤中细菌的大小为 0.5 × 0.8 × 1.0 或 3.5um ,血平板上的菌落为光滑、光泽、凸起、直径 1 ~ 3 毫米
技术资料暂无技术资料 索取技术资料